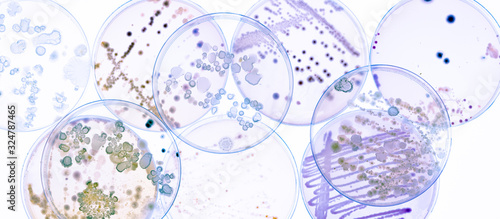

Growing Bacteria in Petri Dishes on agar gel Scientific experiment.
Plik: #324787465 | Autor: luchschenFŁadowanie fotografii...
Chwytając za obrazek można go wykadrować wg. swoich potrzeb!* po wydrukowaniu napis "Adobe Stock" nie będzie widoczny.
+
-
Generuj link do kompozycji
Wybierz produkt i podkład
Typ
Podkład
Laminat
Ustal wymiary
Szerokość
xmax:
Wysokość
max:
Kadr
Pojedynczy obraz

Kadr
Wybierz efekty
Efekt
Odbicie
Obrót
Cena przed rabatem: 0zł
Rabat: 0zł
Cena produktu: 0zł